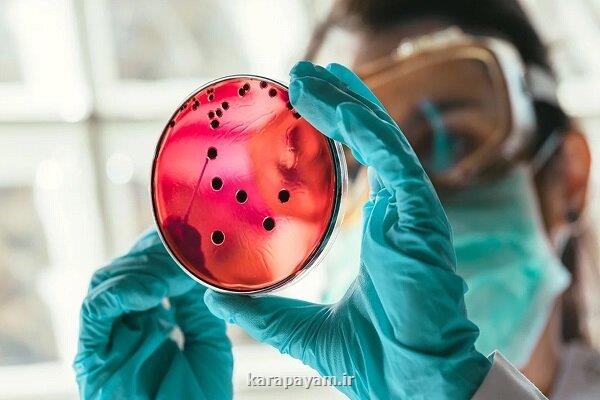
ساخت یک کمپلکس مولکولی برای کمک به بیماران گرفتار سوختگی

حاوی نانوذرات؛
ساخت یک کمپلکس مولکولی برای کمک به بیماران گرفتار سوختگی
کارا پیام: پژوهشگران نشان دادند نوع جدیدی از نانوذرات هیبریدی (کمپلکس مولکولی) که ساخته اند می تواند به بخش لطمه دیده در روده کمک نماید تا زودتر التیام یابند.
به گزارش کارا پیام به نقل از مهر، پژوهشگران چینی نانوذراتی ساختند که می تواند مشکلات ناشی از سوختگی خصوصاً در بخش روده را درمان کند. در این مطالعه نانوذرات سیکلودکسترین کونژوگه شده با لومینل (LCD)، نتایج امیدوارکننده ای برای صدمات شدید سوختگی ارائه داد.
سوختگی شدید می تواند موجب ایجاد مشکلات اساسی، همچون لطمه عمیق در بافت و افزایش ریسک مبتلاشدن به شرایط کشنده مانند سپسیس و نارسایی اندام شود. نگرانی عمده اختلال در سد روده است که منجر به التهاب و مشکلات سیستمیک می شود. شکسته شدن سد روده، به پاتوژن ها اجازه می دهد تا به روده حمله کنند که این مساله وضعیت بیمار را بدتر می کند. باتوجه به محدودیت ها و عوارض جانبی درمان های فعلی، نیاز به روش های درمانی جدید و مؤثرتر وجود دارد.
محققان دانشگاه پزشکی ارتش در چین از یک روش درمانی نوآورانه مبتنی بر نانوذرات رونمایی کردند که بطور قابل توجهی به افراد لطمه دیده در اثر سوختگی که در آنها سد روده شکسته شده، کمک می نماید.
این نانوذرات به شکلی طراحی شده اند که در آن لومینل به سیکلودکسترین متصل است. این کمپلکس مولکولی، ساختاری را به وجود می آورد که بصورت مستقیم سد روده را هدف قرار می دهد. بعد از تجویز، این نانوذرات LCD با کاهش التهاب و استرس اکسیداتیو، دو عامل اصلی که موجب افزایش لطمه به روده در اثر سوختگی می شوند، بیمار را یاری می دهند.
نتایج به دست آمده نشان میدهد که استفاده از این نانوذرات علائمی نظیر کاهش وزن و ناهنجاری های مربوط به نفوذپذیری روده را کم می کنند.
کاربرد موفقیت آمیز نانوذرات LCD در درمان اختلال در سد روده، امید به رفع طیف گسترده ای از شرایط التهابی و اکسیداتیو ناشی از استرس را بیشتر می کند. این درمان نوآورانه می تواند مراقبت از بیماران گرفتار سوختگی شدید را متحول کند.
این مطلب کاراپیام را پسندیدین؟
(1)
(0)
مطالب مرتبط جدید کاراپیام
نظرات بینندگان کاراپیام در مورد این مطلب